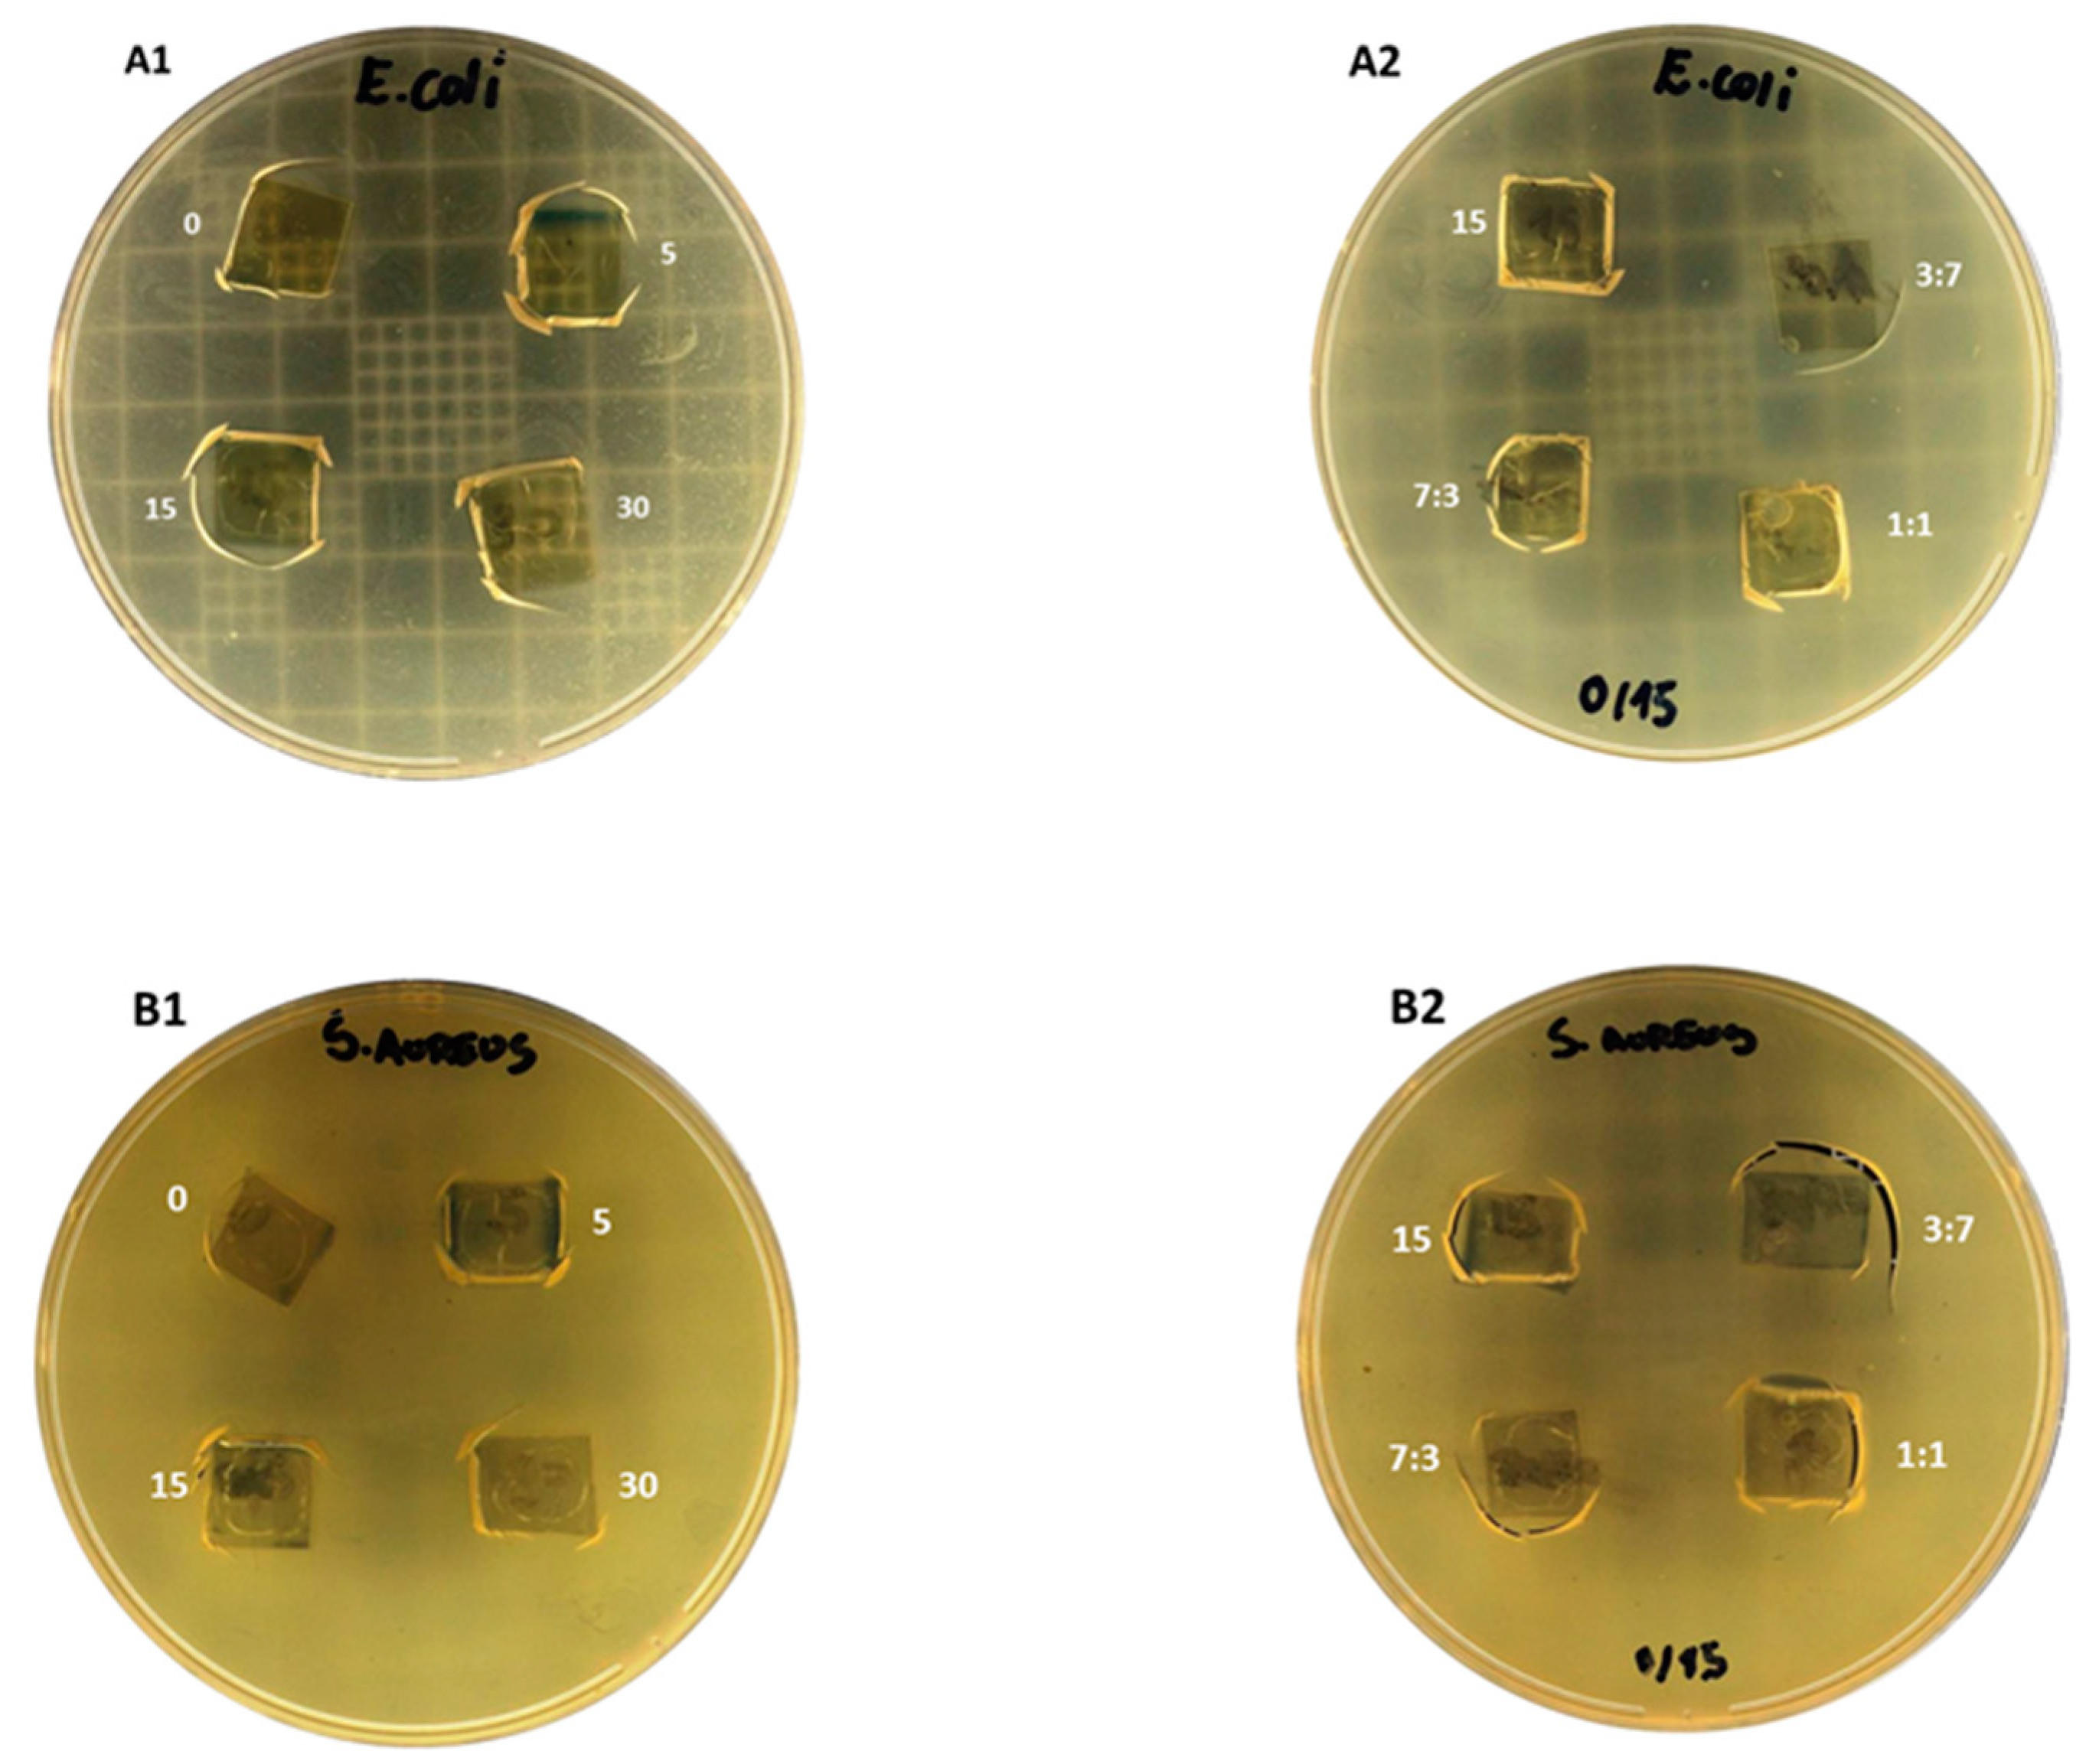
Molecules 24 00127 g004

Edible Chitosan Films and Their Nanosized Counterparts Exhibit Antimicrobial Activity and Enhanced Mechanical and Barrier Properties
Abstract
:1. Introduction
2. Results and Discussion
2.1. Film Thickness and Mechanical Properties
2.2. Water Vapor Permeability and Moisture Sorption Isotherms
2.3. Chitosan-Blend Film Morphology
2.4. Color Properties
2.5. Antimicrobial Activity of Chitosan Films
3. Materials and Methods
3.1. Materials and Solutions
3.2. Biopolymer Fragmentation and Blend Preparation
3.3. Biobased Film Fabrication
3.4. Film Characterization
3.4.1. Thickness Measurements
3.4.2. Mechanical Properties
3.4.3. Water Vapor Permeability
3.4.4. Water Sorption Isotherms
3.4.5. Scanning Electron Microscopy
3.4.6. Color and Opacity
3.5. Antimicrobial Activity
3.6. Statistical Analyses
4. Conclusions
Supplementary Materials
Author Contributions
Funding
Acknowledgments
Conflicts of Interest
References
- Davidovich-Pinhas, M.; Danin-Poleg, Y.; Kashi, Y.; Bianco-Peled, H. Modified chitosan: A step toward improving the properties of antibacterial food packages. Food Pack. Shelf Life 2014, 1, 160–169. [Google Scholar] [CrossRef]
- Chantarasataporn, P.; Yoksan, R.; Visessanguan, W.; Chirachanchai, S. Water-based nano-sized chitin and chitosan as seafood additive through a case study of pacific white shrimp (litopenaeus vannamei). Food Hydrocoll. 2013, 32, 341–348. [Google Scholar] [CrossRef]
- Gomes, L.P.; Paschoalin, V.M.F.; Del Aguila, E.M. Chitosan nanoparticles: Production, physicochemical characteristics and nutraceutical applications. Rev. Virtual Quim. 2017, 9, 387–409. [Google Scholar] [CrossRef]
- Dutta, P.K.; Tripathi, S.; Mehrotra, G.K.; Dutta, J. Perspectives for chitosan based antimicrobial films in food applications. Food Chem. 2009, 114, 1173–1182. [Google Scholar] [CrossRef]
- Cooksey, K. Effectiveness of antimicrobial food packaging materials. Food Addit. Contam. 2005, 22, 980–987. [Google Scholar] [CrossRef] [PubMed]
- Yuan, G.; Lv, H.; Yang, B.; Chen, X.; Sun, H. Physical properties, antioxidant and antimicrobial activity of chitosan films containing carvacrol and pomegranate peel extract. Molecules 2015, 20, 11034–11045. [Google Scholar] [CrossRef] [PubMed]
- Fan, J.-M.; Ma, W.; Liu, G.-Q.; Yin, S.-W.; Tang, C.-H.; Yang, X.-Q. Preparation and characterization of kidney bean protein isolate (kpi)–chitosan (ch) composite films prepared by ultrasonic pretreatment. Food Hydrocoll. 2014, 36, 60–69. [Google Scholar] [CrossRef]
- Santonicola, S.; García Ibarra, V.; Sendón, R.; Mercogliano, R.; Rodríguez-Bernaldo de Quirós, A. Antimicrobial films based on chitosan and methylcellulose containing natamycin for active packaging applications. Coatings 2017, 7, 177. [Google Scholar] [CrossRef]
- Peng, Y.; Li, Y. Combined effects of two kinds of essential oils on physical, mechanical and structural properties of chitosan films. Food Hydrocoll. 2014, 36, 287–293. [Google Scholar] [CrossRef]
- Srinivasa, P.C.; Ramesh, M.N.; Tharanathan, R.N. Effect of plasticizers and fatty acids on mechanical and permeability characteristics of chitosan films. Food Hydrocoll. 2007, 21, 1113–1122. [Google Scholar] [CrossRef]
- Lorevice, M.V.; Otoni, C.G.; Moura, M.R.d.; Mattoso, L.H.C. Chitosan nanoparticles on the improvement of thermal, barrier, and mechanical properties of high- and low-methyl pectin films. Food Hydrocoll. 2016, 52, 732–740. [Google Scholar] [CrossRef]
- Chang, P.R.; Jian, R.; Yu, J.; Ma, X. Fabrication and characterisation of chitosan nanoparticles/plasticised-starch composites. Food Chem. 2010, 120, 736–740. [Google Scholar] [CrossRef]
- Souza, H.K.S.; Campiña, J.M.; Sousa, A.M.M.; Silva, F.; Gonçalves, M.P. Ultrasound-assisted preparation of size-controlled chitosan nanoparticles: Characterization and fabrication of transparent biofilms. Food Hydrocoll. 2013, 31, 227–236. [Google Scholar] [CrossRef]
- Gomes, L.P.; Souza, H.K.; Campiña, J.M.; Andrade, C.T.; Paschoalin, V.M.F.; Silva, A.; Gonçalves, M.P. Tweaking the mechanical and structural properties of colloidal chitosans by sonication. Food Hydrocoll. 2016, 56, 29–40. [Google Scholar] [CrossRef]
- Al-Muhtaseb, A.H.; McMinn, W.A.M.; Magee, T.R.A. Water sorption isotherms of starch powders: Part 1: Mathematical description of experimental data. J. Food Eng. 2004, 61, 297–307. [Google Scholar] [CrossRef]
- Xiao, Q.; Lim, L.-T.; Tong, Q. Properties of pullulan-based blend films as affected by alginate content and relative humidity. Carbohydr. Polym. 2012, 87, 227–234. [Google Scholar] [CrossRef]
- Ziani, K.; Oses, J.; Coma, V.; Maté, J.I. Effect of the presence of glycerol and tween 20 on the chemical and physical properties of films based on chitosan with different degree of deacetylation. LWT-Food Sci. Technol. 2008, 41, 2159–2165. [Google Scholar] [CrossRef]
- Lopez, O.; Garcia, M.A.; Villar, M.A.; Gentili, A.; Rodriguez, M.S.; Albertengo, L. Thermo-compression of biodegradable thermoplastic corn starch films containing chitin and chitosan. LWT-Food Sci. Technol. 2014, 57, 106–115. [Google Scholar] [CrossRef]
- Wang, L.; Dong, Y.; Men, H.; Tong, J.; Zhou, J. Preparation and characterization of active films based on chitosan incorporated tea polyphenols. Food Hydrocoll. 2013, 32, 35–41. [Google Scholar] [CrossRef]
- Khoshgozaran-Abras, S.; Azizi, M.H.; Hamidy, Z.; Bagheripoor-Fallah, N. Mechanical, physicochemical and color properties of chitosan based-films as a function of aloe vera gel incorporation. Carbohydr. Polym. 2012, 87, 2058–2062. [Google Scholar] [CrossRef]
- Gomes, L.P.; Andrade, C.T.; Del Aguila, E.M.; Alexander, C.; Paschoalin, V.M.F. Assessing the antimicrobial activity of chitosan nanoparticles by fluorescence-labeling. Int. J. Biotechnol. Bioeng. 2018, 12, 111–117. [Google Scholar]
- Standard test method for tensile properties of thin plastic sheeting. In Annual Book of ASTM; American Society for Testing Material: Philadelphia, PA, USA, 1996.
- Standard test method for water vapor transmission of material, e96-00. In Annual Book of ASTM Standar; American Society for Testing Material: Philadelphia, PA, USA, 2002.
- Larotonda, F.D.S. Biodegradable Films and Coatings Obtained from Carrageenan from Mastocarpus Stellatus and Starch from Quercus Suber; University of Porto: Porto, Portugal, 2007. [Google Scholar]
- De Sousa, A.M.M. Development and Optimization of an Alternative and Environmentally Friendly Agar Extraction Process. Suitability of the Extracted Agars for the Fabrication of Sustainable Materials; University of Porto: Porto, Portugal, 2014. [Google Scholar]
- Rosa, G.S.; Moraes, M.A.; Pinto, L.A.A. Moisture sorption properties of chitosan. LWT-Food Sci. Technol. 2010, 43, 415–420. [Google Scholar] [CrossRef]
- Thakhiew, W.; Devahastin, S.; Soponronnarit, S. Physical and mechanical properties of chitosan films as affected by drying methods and addition of antimicrobial agent. J. Food Eng. 2013, 119, 140–149. [Google Scholar] [CrossRef]
Sample Availability: Not available. |

| Composites | Blend Ratio | d/mm | WVP∙10−11/g.m−1s−1Pa−1 | GAB Parameters | |||
|---|---|---|---|---|---|---|---|
| C | k | X0 | R2 | ||||
| NS | - | 0.028 ± 0.00 A | 14.4 ± 0.01 A | 0.017 | 0.9 | 0.12 | 0.991 |
| NS/S5min | 7:3 | 0.023 ± 0.002 a | 7.9 ± 1.1 a | 2.84 | 1.0 | 0.005 | 0.981 |
| 1:1 | 0.025 ± 0.003 a | 9.5 ± 0.4 a | 1.62 | 1.0 | 0.01 | 0.991 | |
| 3:7 | 0.020 ± 0.001 a | 5.9 ± 0.7 b | 1.08 | 1.0 | 0.01 | 0.982 | |
| S5min | - | 0.008 ± 0.001 b | 10.8 ± 0.9 a | 2.82 | 0.9 | 0.01 | 0.997 |
| NS/S15min | 7:3 | 0.020 ± 0.001 a | 13.2 ± 3.2 A,a | 5.02 | 1.07 | 0.01 | 0.995 |
| 1:1 | 0.017 ± 0.002 a | 12.1 ± 0.13 a | 3.46 | 0.88 | 0.01 | 0.995 | |
| 3:7 | 0.022 ± 0.003 a | 9.1 ± 0.7 a | 2.24 | 0.95 | 0.10 | 0.999 | |
| S15min | - | 0.008 ± 0.0001 b | 7.8 ± 0.0 a | 3.09 | 1.05 | 0.003 | 0.997 |
| NS/S30min | 7:3 | 0.013 ± 0.002 a | 8. 7 ± 0.6 a | 0.002 | 1.0 | 0.1 | 0.993 |
| 1:1 | 0.018 ± 0.001 a | 6. 3 ± 2.4 a | 0.002 | 1.0 | 0.1 | 0.984 | |
| 3:7 | 0.011 ± 0.001 b | 3.9 ± 0.04 b | 0.013 | 0.9 | 0.1 | 0.973 | |
| S30min | - | 0.010 ± 0.002 b | 7.4 ± 0.02 a | 11.6 | 1.0 | 0.002 | 0.998 |
| Blend Ratio | L* | a* | b* | ΔE* | Opacity | |
|---|---|---|---|---|---|---|
| NS | - | 95.67 ± 0.2 A | −0.302 ± 0.04 A | 3.26 ± 0.2 A | 2.1 ± 0.3 A | 10.4 ± 0.2 A |
| NS/S5min | 7:3 | 97.22 ± 0.2 a | −0.21 ± 0.1 b | 3.05 ± 0.8 A,c | 1.3 ± 0.8 A,b | - |
| 1:1 | 95.38 ± 0.1 A,c | −0.27 ± 0.06 b | 3.4 ± 0.2 b | 2.4 ± 0.2 A,a | 12.2 ± 1.9 A,a | |
| 3:7 | 96.88 ± 0.8 b | −0.33 ± 0.3 A,c | 3.9 ± 1.7 a | 2.3 ± 1.8 A,a | - | |
| S5min | - | 96.17 ± 0.5 A,b | 0.002 ± 0.008 a | 2.6 ± 0.1 d | 1.3 ± 0.4 b | 12.3 ± 0.8 a |
| NS/S15min | 7:3 | 91.30 ± 0.8 c | −0.53 ± 0.06 c | 5.52 ± 0.2 a | 7.0 ± 0.7 a | 13.4 ± 0.6 a |
| 1:1 | 92.65 ± 0.8 b | −0.52 ± 0.07 c | 5.05 ± 0.2 b | 5.6 ± 0.7 b | 13.2 ± 0.4 a | |
| 3:7 | 95.24 ± 1.0 A,a | −0.26 ± 0.04 A,b | 3.72 ± 0.2 c | 2.8 ± 0.8 A,c | 10.4 ± 1.5 A,b | |
| S15min | - | 96.25 ± 0.4 A,a | 0.07 ± 0.04 a | 2.57 ± 0.3 d | 1.8 ± 0.5 A,d | 12.3 ± 0.7 a |
| NS/S30min | 7:3 | 95.01 ± 0.6 A,a | −0.11 ± 0.1 a | 3.39 ± 0.4 A,c | 2.6 ± 0.8 A,c | 10.7 ± 0.9 A,b |
| 1:1 | 95.86 ± 0.7 A,a | −0.18 ± 0.08 a | 3.42 ± 0.2 A,c | 2.1 ± 0.5 A,c | 12.2 ± 1.1 a | |
| 3:7 | 94.63 ± 0.7 b | −0.32 ± 0.04 A,b | 3.90 ± 0.3 b | 3.3 ± 0.7 b | 12.0 ± 1.1 a | |
| S30min | - | 93.34 ± 0.6 b | −0.56 ± 0.06 c | 5.2 ± 0.3 a | 5.1 ± 0.7 a | 12.6 ± 0.6 a |
© 2018 by the authors. Licensee MDPI, Basel, Switzerland. This article is an open access article distributed under the terms and conditions of the Creative Commons Attribution (CC BY) license (http://creativecommons.org/licenses/by/4.0/).
Share and Cite
Gomes, L.P.; Souza, H.K.S.; Campiña, J.M.; Andrade, C.T.; Silva, A.F.; Gonçalves, M.P.; Paschoalin, V.M.F. Edible Chitosan Films and Their Nanosized Counterparts Exhibit Antimicrobial Activity and Enhanced Mechanical and Barrier Properties. Molecules 2019, 24, 127. https://doi.org/10.3390/molecules24010127
Gomes LP, Souza HKS, Campiña JM, Andrade CT, Silva AF, Gonçalves MP, Paschoalin VMF. Edible Chitosan Films and Their Nanosized Counterparts Exhibit Antimicrobial Activity and Enhanced Mechanical and Barrier Properties. Molecules. 2019; 24(1):127. https://doi.org/10.3390/molecules24010127
Chicago/Turabian StyleGomes, Laidson P., Hiléia K. S. Souza, José M. Campiña, Cristina T. Andrade, António F. Silva, Maria P. Gonçalves, and Vania M. Flosi Paschoalin. 2019. "Edible Chitosan Films and Their Nanosized Counterparts Exhibit Antimicrobial Activity and Enhanced Mechanical and Barrier Properties" Molecules 24, no. 1: 127. https://doi.org/10.3390/molecules24010127








